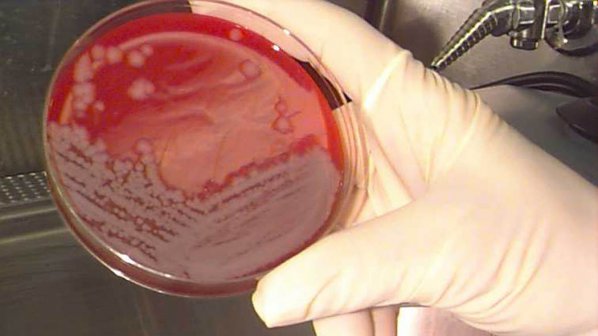

40-годишен мъж от Шуменско се е заразил с антракс от заразено животно, съобщават от Националната референтна лаборатория за особено опасни бактериални инфекции.
Мъжът е потърсил незабавно медицинска помощ.
Специалистите обясняват, че спорите се намират в почвата и когато вали обилно излизат на повърхността Това би могло да се случи и при сухо време, като животните ги изяждат с тревата.
Най-опасно за човек е когато консумира недопечено месо от заразено животно, пише “Блиц”.
Междувременно стана ясно, че в село Загориче освен карантина заради антракс, има и проблеми с водата. Местните жители се възмущават, че вече няколко дни стоят без вода заради техническа неизправност с помпената станция.
Оказа се, че помпите на съоръжението са преустановили дейност заради спиране на тока. Освен това потреблението на вода се увеличило и това допълнително усложнило ситуацията.
Жителите са готови да се вдигнат на протест, тъй като никой не се интересува от проблемите им. Кметът на селото, поставено под карантина, пък бил готов веднага да обяви бедствено положение, тъй като при тези високи температури е много тежко без вода.
източник: pravda.bg




